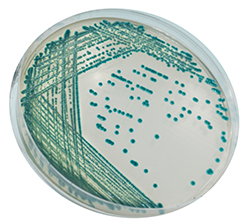
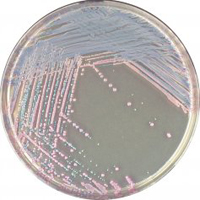

Clinical Microbiology
Products relevant to clinical microbiology
CHROMagar Strep B 5000ml + supplements
- Unit Quantity: 1
CHROMagar mSuperCARBA 5000ml
- Unit Quantity: 1
CHROMagar Serratia 5000ml
- Unit Quantity: 1
CHROMagar Strep A 5000ml
- Unit Quantity: 1
CHROMagar STEC 5000ml + supplement
- Unit Quantity: 1
CHROMagar Staph Aureus 5000ml
- Unit Quantity: 1
CHROMagar VRE 5000ml + supplement
- Unit Quantity: 1
CHROMagar Y. enterocolitica 5000ml
- Unit Quantity: 1